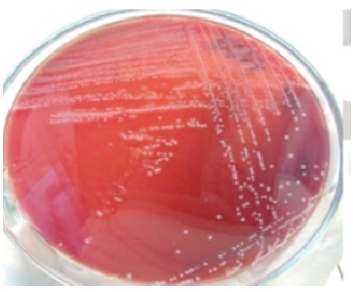
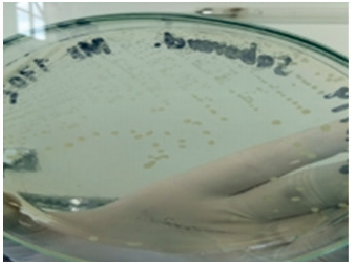

RESUMEN: El presente artículo tiene como objetivo presentar el caso de una yegua criolla colombiana de 15 años con historial de abortos y nula obtención de embriones, donde fueron realizados como métodos diagnósticos la evaluación del sistema genital externo e interno, ultrasonografia, citología, cultivo y biopsia endometrial; la cual reportó endometritis crónica de clasificación II B, asociada edema tipo 4, y estableciendo un pronóstico reservado para la reproducción, después de comprobarse la endometritis fúngica. El tratamiento consistió en la utilización de complejos vitamínicos, medicina biorreguladora, terapia antimicótica y antibiótica, nutraceúticos, minerales, y lavados intrauterinos. Posterior a la medicación y tres intervalos ovulatorios consecutivos, fueron recuperados y transferidos exitosamente cuatro embriones, de los cuales tres llegaron a término, demostrando así la recuperación de la función endometrial, gracias a la identificación de los microorganismos involucrados y el establecimiento de una terapia adecuada y complementada. La endometritis se define como la inflamación del endometrio, y es considerada una de las principales causas de sub e infertilidad en la yegua, que generan pérdidas económicas significativas, con una incidencia del 10 al 15 %. Existen diferentes etiologías, destacándose la mala conformación del perineo, útero abdominal, pérdida de la actividad miometrial, número de montas, factores moleculares y genéticos, y la presencia de bacterias y hongos.
Palabras clave: Endometritis crónica, yegua, citología uterina, biopsia endometrial.
ABSTRACT: The objective of this article is to present the case of a 15-year-old Colombian criollo mare with a history of abortions and no embryo obtaining, where the evaluation of the external and internal genital system, ultrasonography, cytology, culture and endometrial biopsy were performed as diagnostic methods; which reported chronic endometritis of classification II B, associated with type 4 edema, and establishing a reserved prognosis for reproduction, after verifying fungal endometritis. The treatment consisted of the use of vitamin complexes, bioregulatory medicine, antifungal and antibiotic therapy, nutraceuticals, minerals, and intrauterine washings. After the medication and three consecutive ovulatory intervals, four embryos were successfully recovered and transferred, of which three reached term, thus demonstrating the recovery of endometrial function, thanks to the identification of the microorganisms involved and the establishment of adequate therapy. And complemented. Endometritis is defined as inflammation of the endometrium, and is considered one of the main causes of sub and infertility in the mare, which generate significant economic losses, with an incidence of 10 to 15 %. There are different etiologies, highlighting the malconformation of the perineum, abdominal uterus, loss of myometrial activity, number of mounts, molecular and genetic factors, and the presence of bacteria and fungi.
keywords: Chronic endometritis, mare, uterine cytology, endometrial biopsy.
RESUMO: O objetivo deste artigo é apresentar o caso de uma égua crioula colombiana de 15 anos com histórico de abortos e não obtenção de embrião, onde foi realizada avaliação do sistema genital externo e interno, ultrassonografia, citologia, cultura e biópsia endometrial realizados como métodos diagnósticos.; que relataram endometrite crônica de classificação II B, associada a edema tipo 4, estabelecendo prognóstico reservado para reprodução, após constatação de endometrite fúngica. O tratamento consistiu no uso de complexos vitaminicos, medicamentos biorreguladores, antifúngicos e antibióticos, nutracêuticos, minerais e lavagens intrauterinas. Após a medicação e três intervalos ovulatórios consecutivos, quatro embriões foram recuperados e transferidos com sucesso, dos quais três chegaram a termo, demonstrando assim a recuperação da função endometrial, graças à identificação dos microorganismos envolvidos e ao estabelecimento de terapia adequada. A endometrite é definida como a inflamação do endométrio, sendo considerada uma das principais causas de sub e infertilidade na égua, que geram perdas econômicas significativas, com incidência de 10 a 15 %. Existem diferentes etiologias, destacando-se a má conformação do perineo, útero abdominal, perda da atividade miometrial, número de montas, fatores moleculares e genéticos, além da presença de bactérias e fungos.
Palavras-chave: Endometrite crônica, égua, citologia uterina, biópsia endometrial.
Estudio de caso
Reporte de caso clínico: endometritis crónica en una yegua criolla colombiana
Case report: chronic endometritis in a Colombian creole mare
Relato de caso: endometrite crônica em uma égua crioula colombiana
Recepción: 20 Septiembre 2022
Recibido del documento revisado: 02 Noviembre 2022
Aprobación: 10 Noviembre 2022
La agroindustria del caballo representa grandes ingresos en el sector ecuestre en el mundo, generando trabajo a diferentes profesionales que actúan en diversas áreas de conocimiento, como medicina del deporte, ortopedia, clinica, cirugia, nutrición, y reproducción entre las áreas más específicas de trabajo en todo en el contexto de la equinocultura. Para lograr excelente eficiencia productiva se requiere alcanzar óptimas tasas de fertilidad que garanticen una adecuada eficiencia reproductiva, la cual puede ser posible con conocimientos amplios y específicos en la ciclicidad reproductiva, dinámica folicular, ciclo estral e inclusive en las características específicas individuales de tamaños y diámetros de los folículos preovulatorios, mecanismos de selección, dominancia, e inclusive la ovulación, ya que entre menor sea el intervalo inseminación y ovulación, se obtienen mejores indices de fertilidad (Ginther et al., 2008).
En Colombia, se tiene un núcleo representativo de equinos en todo el territorio nacional; aproximadamente existen 1584000 ejemplares equinos, lo cual implica que se requiera el uso de técnicas de reproducción asistida como la inseminación artificial que garantice el mejoramiento genético de criaderos, utilizando semen de caballos considerados genéticamente superiores en los procesos reproductivos, para incrementar así la presión de selección genética y mejorar la cría de caballos (ICA, 2018). Cuando hay yeguas susceptibles al proceso de endometritis, se debe tener en cuenta que, al depositar espermatozoides en el útero al momento de la inseminación, se genera una respuesta inflamatoria, los mecanismos de defensa intrauterina se exacerban y se altera tanto la respuesta humoral como celular (LeBlanc, 2008).
La infertilidad en las yeguas sigue siendo una causa de gran pérdida económica en la cria de caballos, lo que hace imposible producir un potro por yegua cada año. Desde los últimos 50 años hasta hoy, la endometritis se considera una de las principales causas de infertilidad en yeguas, además de ser uno de los mayores problemas en la clinica de caballos (Papa et al., 2014; Liu y Troedsson, 2008). Dentro de los principales signos clinicos ligados a la subfertilidad observados en yeguas con presencia de endometritis, encuentran la irregularidad de los ciclos reproductivos, las pérdidas embrionarias tempranas y abortos. Si bien hay casos en que la endometritis es aséptica, usualmente son de origen bacteriano y se relacionan con una via de ingreso de tipo ascendente, es decir, microorganismos habituales de la región del perineo que ingresan al tracto reproductivo, producto de una mala conformación anatómica a nivel vulvar, vestibular y principalmente del cérvix, sumado a una alteración inmunitaria en el útero. La flora patógena normalmente encontrada en en-dometritis bacterianas, está representada por Streptococcus B hemolitico, Pseudomona aeruginosa, Klebsiella pneumoniae, Escherichia coli, Staphylococcus coagulasa negativo y Proteus spp (Liu y Troedsson, 2008).
La endometritis bacteriana es considerada como una de las causas más representativas que generan sub e infertilidad en la yegua, por lo cual adquiere importancia en el manejo reproductivo, no solo debido a las pérdidas económicas significativas que puede representar en la cría de caballos alrededor del mundo, sino la cantidad de potros o de embriones que dejan de nacer en países estacionales y países no estacionales. Los procesos infecciosos-inflamatorios ocupan del 25 % al 60 % de las causas de infertilidad de los cuales la endometritis tiene una prevalencia del 30 % en las patologías reproductivas de la yegua (Causey et al., 2008).
Por su parte, dada la importancia de la evaluación histopatológica del endometrio en el diagnóstico y pronóstico, la biopsia se posesiona como el método más preciso para evaluar la morfo-funcionalidad del endometrio. Asimismo, conocer y entender la fisiopatología de esta enfermedad e identificar los factores predisponentes, es fundamental para su monitoreo, control y diagnóstico (Hurtgen, 2006).
Las condiciones inflamatorias del útero se pueden clasificar como agudas, crónicas, activas o subclinicas y persistentes (Hurtgen, 2006; Causey et al., 2008), La endometritis crónica es causada por microorganismos, con mayor frecuencia Streptococcus zooepidemicus y E. coli, y su ocurrencia es independiente de la etapa del ciclo o tiempo de apareamiento (Katila, 2016), Además, existen diferentes etiologias que pueden ser de naturaleza bacteriana, fúngica, viral e inducida por el apareamiento; también, se puede llegar a pensar en factores moleculares y/o genéticos involucrados (Katila, 2016).
Los tratamientos utilizados en la endometritis incluyen lavados uterinos, administración de medicamentos ecbólicos, e infusiones intrauterinas de antibióticos. Estudios clinicos recientes han demostrado que la utilización de compuestos mucoliticos en conjunto con lavados uterinos y la administración correcta de antibióticos (intrauterinos, sistémicos o combinados), mejora las tazas de preñez de las yeguas que presentan historial de infertilidad a causa de esta patologia (Leblanc y Causey, 2009). Sin embargo, la mayoria de los estudios no presentan un cuadro clinico de endometritis fúngica que tenga un impacto directo en la función reproductiva, determinándose una endometritis crónica de dificil tratamiento e identificación del microorganismo específico causal de este tipo de endometritis atipica en la yegua, que genere una afectación directa en el endometrio y comprometa su función a tal punto de tener un pronóstico desfavorable a la reproducción (Leblanc et al., 1998).
La administración de los antibióticos debe ser determinada por los resultados de las pruebas de sensibilidad o antibiograma aplicadas para cada caso, ya que estos representan una ayuda eficaz en el tratamiento de la endometritis infecciosa, crónica e inducida por el apareamiento (Leblanc et al., 1998).
En la actualidad, no se tiene establecido un protocolo terapéutico que demuestre mayor eficacia en el tratamiento de la endometritis bacteriana ni mucho menos para el tratamiento eficaz de la endometritis fúngica (Hurtgen, 2006), por lo tanto, el propósito de este relato de caso es presentar el cuadro clinico de una yegua con endometritis fúngica, su evolución, identificación, y manejo clínico terapéutico.
Una yegua de aproximadamente 15 años de grupo racial Criollo colombiano, con un peso de 330 kg, fue presentada para un examen gineco-obstétrico de rutina; el veterinario remitente reportó que la yegua 6 años atrás presentó dos abortos y que, en la actualidad, no tenia éxito en la obtención de embriones.
Al momento del examen gineco-obstétrico, la yegua presentaba una ligera distopia vulvar y en la evaluación cervical se evidenciaron adherencias, lo que posiblemente estaba impidiendo llevar a término la gestación. Se encontraba con esquema de vacunación y vermifugación completo, y tenia historial de obesidad.

Los hallazgos del examen físico fueron: 43 l/ pm, 23 r/pm, temperatura rectal de 37.8 °C y tiempo de llenado capilar de 2 segundos, pulsos digitales (anteriores y posteriores) negativos. En el histórico reproductivo se reportan lavados de embriones positivos y dos abortos, no se reporta la realización de citologías. Además, la yegua presentaba el útero distendido con áreas compatibles con edema de tipo patológico. En cuanto a los ovarios, en el izquierdo se detectó un folículo de 48 mm de consistencia normal y el derecho estaba multifolicular, también de consistencia normal. No hubo dolor a la palpación.
La yegua fue diagnosticada el 13 de noviembre de 2019, se realizaron pruebas diagnósticas y, en el mes de diciembre de 2019, se estableció el diagnóstico definitivo para poder dar inicio en febrero de 2020 con el tratamiento, el cual se extendió hasta junio; se dejaron pasar dos celos consecutivos y en agosto de 2020 se iniciaron los protocolos de sincronización de celo, a partir de septiembre de 2022 se realizaron los primeros lavados de embriones y se recuperaron tres embriones de los cuales fueron transferidos y pegaron dos embriones en octubre 2020; posteriormente, se diagnosticaron receptoras con embriones en enero de 2021 y en octubre de 2021 nacieron dos potros saludables de estas yeguas receptoras.
Como plan diagnóstico, se decidió realizar: exámenes de laboratorio (hemograma completo y quimica sanguinea), ultrasonografia, citologia uterina, cultivo y biopsia endometrial.
Mediante la ultrasonografía, se observaron estructuras como folículos en ovarios, cérvix, cuerpo del útero, y cuernos uterinos con cambios evidentes y compatibles con un proceso patológico, edema intrauterino tipo IV; ese encontró, además, la presencia de quistes endometriales y acumulación de líquido en los cuernos y el cuerpo del útero.

La citologia fue realizada mediante swab endometrial y, posteriormente, fue empleada la técnica de tinción de Diff Quick. En ella se encontró gran cantidad de polimorfonucleares neutrófilos (PMN), nidos bacterianos, levaduras e hifas de hongos.



Posterior al swab endometrial, las muestras fueron colocadas en medio Stuart de transporte e incubadas por 48 horas en estufa; luego, se realizó la siembra en medios Agar Mconkey, Agar sangre, Agar EMB y Agar Sabourau, para detectar y evidenciar el crecimiento bacteriano y de levaduras. En los cultivos endometriales, se aislaron: bacilos gram negativos, bacilos gram positivos y levaduras.





La biopsia uterina fue realizada a través de la extirpación de un fragmento uterino con pinza Yoemen fórceps específica para equinos. La muestra se fijó en formol salino tamponado al 10 % y, posteriormente, fue realizada la lectura a través del corte histopatológico. En ella fue posible evidenciar la superficie endometrial con cambios histopatológicos significativos y un proceso inflamatorio crónico, con edema de leve a moderado, leve fibrosis periglandular y dilatación glandular quística. El reporte de la biopsia endometrial fue el siguiente:
Muestra de endometrio con integridad del epitelio.
Severa dilatación de vasos linfáticos y edema en lámina propia.
Grupos de glándulas endometriales, algunas con contenido proteináceo en su interior.
Atrofia de nidos glandulares con presencia de cuatro fibroblastos periglandulares en algunos grupos de glándulas endometriales.
Infiltrados linfoides en lámina propia.
Dilatación quística de glándulas endome-triales.
Moderada congestión.
Con base en los hallazgos del examen clínico, el histórico reproductivo y lo encontrado en los planes diagnósticos, se llegó a la conclusión de que la yegua presentaba una infección uterina (endometritis fúngica). Finalmente, y en conjunto con el resultado de la histopatología, se llegó al siguiente diagnóstico: Endometritis Crónica de tipo fúngica con clasificación del endometrio II B. El pronóstico fue reservado para la reproducción.
Posterior a lo anterior, se instauró el siguiente tratamiento:
1. Aceite de oliva extra virgen: se suministró 40 ml diarios, 20 ml en la mañana y 20 ml en la tarde durante 40 días, este se empleó con el objetivo de incrementar los niveles de omega 3 que es un potente antioxidante a nivel endometrial.
2. Vigantol®: se aplicaron únicamente 5 ml intramuscular profundo cada 65 días (solo dos aplicaciones), con el objetivo de lograr la epitelización y remodelación del endometrio al tener elevada concentración de vitamina A, D y E.
3. Vitasel®: se aplicaron solo 5 ml intramuscular profundo cada 24 horas, 3 días consecutivos, y se repitió a los 45 días, este medicamento contiene gran cantidad de minerales como zinc, cobre, magnesio, entre otros que son cofactores y actúan regulando los procesos enzimáticos y auxiliando en la epitelización.
4. Protocolo con medicina bioreguladora: se realizó la aplicación de: Coenzyme®, Ovarium compositum®, Heepel®, Trau-meel®, Mucosa compositum®, Lachesis® y Gallium®; una ampolla de cada una, tres veces por semana, disueltas en 250 ml de ringer lactato, en las horas de la tarde, durante un mes.
Nota: para un mayor éxito del tratamiento, se recomendó un segundo protocolo de medicina biorreguladora con los siguientes productos: Coenzyme®, Ovarium composi-tum®, Traumeel®, Mucosa compositum®, Lachesis®, Gallium®; estos productos deben aplicarse por vía intrauterina durante tres días consecutivos cuando la yegua esté en celo. Se aplican con un catéter de inseminación y el tratamiento se debe realizar durante los siguientes dos celos.
5. Protocolo para retirar el biofilm: se disolvió un sobre de N-Acetil Cisteína de 600 mg en 150 ml de ringer lactato tibio a 35 grados. Posteriormente, se realizó una infusión uterina durante 15 a 20 minutos. Finalmente, se procedió a lavar el útero con dos litros de ringer lactato.
6. Terapia antimicótica:
a. Lavado. Se realizaron los siguientes lavados:
20 ml de peróxido de hidrógeno disueltos en un litro de ringer lactato, con posterior infusión uterina, la cual, apenas se terminó, se retiró y se procedió a lavar el útero con cuatro litros de ringer lactato.
Se disolvieron 50 ml de ácido acético en un litro de ringer lactato, con posterior infusión uterina, la cual, apenas se terminó, se retiró y se procedió a lavar el útero con cuatro litros de ringer lactato.
b. Terapia farmacológica. Fluconazol a una dosis de 10mg/ kg, vía oral durante 12 días.
7. Terapia antibiótica:
a. Ciprofloxacina. Dosis de 5 mg/kg, vía oral durante 4 días.
b. Ceftiofur sódico. Dosis de 5 mg/kg, intramuscular profundo durante 5 días consecutivos.

Durante el examen gineco-obstétrico de rutina en la yegua, los hallazgos clínicos más comunes que sugieren endometritis y justifican la instauración de un plan diagnóstico, incluyen: gran volumen o líquido ecogénico en la luz uterina durante el estro, edema uterino excesivo, cualquier líquido presente en la luz uterina en el diestro, y cérvix hiperémico con o sin secreción del orificio cervical. En el caso de la yegua del presente reporte, fue posible evidenciar ciclos estrales cortos, repetición e incremento en el número de servicios, lavados de embriones negativos, inseminación con tres sementales diferentes con nula recuperación de embriones, lo cual indicaba una posible infección que comprometía el proceso de la concepción o fertilización de la yegua al generar un ambiente uterino hostil para la supervivencia de los espermatozoides.
El diagnóstico de la endometritis se basará principalmente en la historia clínica del animal, si ha presentado episodios anteriores de subfertilidad, acumulación de líquido en útero, etc. (Carnota, 2019).
La sensibilidad y especificidad de los métodos de diagnóstico, influyen en la percepción de la prevalencia de endometritis y la necesidad de tratar al animal. Los métodos de examen se pueden dividir en tres grupos: examen clínico (palpación transrectal y ecografía, examen transvaginal digitalmente o con espéculo, inspección del área perineal y flujo vaginal y endoscopia) y muestreo del útero (biopsia, hisopo, cepillo, lavado de bajo volumen). Las muestras pueden enviarse para examen cito-lógico y bacteriológico; la histología se realiza habitualmente en biopsias (Katila, 2016).
Las yeguas con endometritis clínica son las más fáciles de diagnosticar, por la presencia de signos clínicos. Entre los signos más característicos, se encuentra la acumulación de líquido intrauterino. Otros, de los signos que pueden aparecer en yeguas con endometritis son: vaginitis, flujo vaginal e intervalos cortos entre estros. A diferencia de las anteriores, las yeguas que presentan endometritis subclínica, suponen un problema para el veterinario porque, en ocasiones, el único signo que presentan, a mayores de la subfertilidad, es un pequeño edema uterino (Carnota, 2019).
La utilidad de los métodos diagnósticos aumenta cuando se realizan en conjunto, motivo por el cual es importante conocer el proceso de cada prueba, así como los resultados que estas arrojan y la forma en la que se interpretan.
Generalmente, las endometritis son el resultado de la interacción entre un agente causal, que puede ser de origen infeccioso o no, y los mecanismos de defensa uterina. La cantidad de agente causal que penetre en el útero, su virulencia en el caso de agentes infecciosos, y la presencia de factores predisponentes que reduzcan la efectividad de los mecanismos de defensa, serán los que determinen la aparición de esta patología (Carnota, 2019).
En un entorno clínico, una opción para la toma de muestras es a través de un hisopo de cultivo protegido y un cepillo de citología para el cultivo microbiano y la evaluación citológica (Ferris et al., 2012), los cuales se utilizaron en este caso, y evidenciaron la presencia de polimorfonucleares en la citología, y de bacterias en el cultivo. Se ha informado la correlación entre la susceptibilidad a la infección y los cambios histológicos. El examen citológico de células polimorfonucleares en un frotis teñido obtenido de la superficie del endometrio es una herramienta fácil para el diagnóstico rápido de inflamación uterina en condiciones prácticas de campo. Sin embargo, el examen citológico e histológico solo indica que la yegua tiene inflamación, pero no proporciona la etiología de la afección (Nielsen, 2005), por lo cual es importante acompañar los métodos diagnósticos con un cultivo uterino, los cuales nos ayudan a tipificar las bacterias especificas en el endometrio; en este caso en particular se aisló E. Coli y Klebsiella ssp. La presencia de este tipo de bacterias en el útero, proporciona un ambiente hostil para los espermatozoides, ya que estas bacterias se adhieren al endometrio y generan una serie de respuestas inmunológicas exacerbadas que contribuyen a la liberación de mediadores bioquímicos de la inflamación, como las citoquinas que perjudican ampliamente el ambiente endometrial, comprometiendo los mecanismos normales de defensa, generando un proceso inflamatorio que puede ser agudo o crónico, el cual influye en la tasa de concepción de la yegua (Katila, 2016).
Algo que pudo exacerbar la respuesta inmunológica en la yegua de este caso fue, la cantidad de servicios que se realizaron como tentativas para lograr alcanzar una preñez, sin embargo, esto posiblemente genere una respuesta inflamatoria aguda después del apareamiento, que se caracteriza, entre otras cosas, por la afluencia de PMN, que son importantes en el mecanismo de defensa fisiológico. En yeguas sanas, la inflamación desaparece en 48 horas post servicio, mientras que la inflamación persiste en yeguas susceptibles a endometritis, esto se denomina endometritis persistente posterior a la reproducción (PPBE) (Katila, 2016). Históricamente, las yeguas han sido clasificadas como susceptibles a la endometritis persistente inducida por apareamiento (PMIE) cuando tienen una edad avanzada, que es el caso de esta yegua; sin embargo, otros factores como aumento en el número de partos, presencia de cambios inflamatorios crónicos dentro del endometrio, presencia de líquido intrauterino en diestro, la imposibilidad de eliminar bacterias intrauterinas, o la capacidad para eliminar el radiocoloide intrauterino en 2 h son también posibles causas de endometritis post servicio (Bucca et al., 2008).
Otros factores predisponentes que pueden generar susceptibilidad a endometritis, son las anomalías de conformación perineal, las cuales pueden adquirirse por traumatismos durante la reproducción o el parto. Una consecuencia común del trauma perineal, es la ruptura de las barreras protectoras que previenen la contaminación del tracto reproductivo craneal. La vulva proporciona la primera barrera eficaz que protege al útero de infecciones ascendentes. Los labios anatómicamente ideales están llenos y firmes y se unen uniformemente en la línea media, y el 80 % o más de la abertura vulvar está por debajo del borde de la pelvis (Papa et al., 2014). Sin embargo, en esta yegua no se observó ningún tipo de anormalidad vulvar ni en la conformación de la región perineal.
Si el cierre vulvar es incompetente, puede ocurrir aspiración de aire y, por lo tanto, contaminación de la vagina. La vaginitis inicial puede dar lugar a cervicitis y endometritis aguda, que en consecuencia darán lugar a subfertilidad. Por lo tanto, los genitales externos (vulva) deben evaluarse para determinar la conformación y el tono muscular. La disminución del tono muscular que se produce con la edad, puede llevar a un compromiso del cierre vulvar y predisponen a la neumovagina o "succión del aire" (Nielsen, 2005). La mala conformación lleva a cambios en la inclinación de la vulva, por lo cual la yegua puede presentar una infección ascendente del tracto reproductivo.
La conformación vulvar defectuosa puede ser congénita, que es muy rara, o adquirida, causada por estiramiento vulvar después varios partos, lesión del tejido perineal por lesiones durante el parto o la reproducción que generan la fístula recto vaginal, o mala condición corporal (Papa et al., 2014).
Otro aspecto importante que puede ser determinante en la presentación de la endometritis, es la deficiente conformación anatómica, esto puede visualizarse cuando en una yegua el útero se encuentra completamente abdominal, aunque esto no se observó en el caso reportado. Woodward (2012) encontró que las yeguas con mala conformación tendían a padecer una mayor incidencia de endometritis, argumentó que las yeguas son clasificadas como susceptibles por carecer de una inflamación inducida clara dentro de las 96 horas después de la inoculación de bacterias o espermatozoides (Woodward, 2012).
La posición del útero es un factor expuesto por Leblanc (1998), quien afirma que, según la posición de este en la cavidad abdominal, puede haber un factor relevante en la capacidad para disminuir la inflamación, este autor determinó que las yeguas con menos éxito en la limpieza de algún radiocoloide muestran una caída pendular del útero por debajo del borde de la pelvis (Leblanc y Causey, 2009).
Además de los factores arriba descritos, la elevada concentración espermática tiene un importante papel en la inflamación del endometrio que ocurre después de la monta o inseminación artificial. En la yegua de este caso, nunca se utilizó más de 500 millones de espermatozoides motiles progresivos viables totales en la dosis inseminante, por tanto, se descartó este aspecto; sin embargo, es importante relatar que muchos estudios han evidenciado un aparente reclutamiento de PMN desde la sangre a la luz uterina, generado por los espermatozoides. Además, es sabido que la concentración espermática y el número de espermatozoides pueden dar lugar a diferentes grados de inflamación del útero. A diferencia de lo que se puede pensar, se sabe que el plasma seminal no da lugar a una respuesta inflamatoria como la producida por los espermatozoides, por lo que estos últimos son los únicos responsables de la inflamación que tiene lugar en el útero. Los componentes de la inseminación provocan una respuesta inflamatoria en el útero, que es más rápida e intensa a mayor concentración de espermatozoides (Carnota, 2019), independientemente de la viabilidad espermática (Díaz, 2012).
Hay que tener en cuenta que la deposición del semen en la yegua es siempre intrauterina, lo que quiere decir que tanto los componentes seminales como los bacterianos contaminarán el lumen uterino y provocarán, consecuentemente, inflamación. Inicialmente, se pensó que las causantes de la respuesta inflamatoria eran las bacterias. Sin embargo, los estudios han demostrado que los propios espermatozoides pueden ser los causantes de dicha reacción. Del global del eyaculado, sólo una pequeña parte asciende hasta los oviductos donde se lleva a cabo la fertilización, mientras que la mayoría queda acumulada en el cuerpo uterino donde desencadena una respuesta inflamatoria aguda. La respuesta inflamatoria uterina tiene como objetivo la eliminación del exceso de espermatozoides, plasma seminal y contaminantes antes de que el embrión descienda (Díaz, 2012).
La endometritis micótica es una causa importante de subfertilidad en la yegua, debido a las dificultades en la detección inicial de la infección y la recurrencia de la infección después del tratamiento (Ferris et al., 2012). Por otra parte, cabe resaltar que la infección uterina por hongos es un problema poco común en la yegua, con una incidencia reportada de solo 1-5 % de endometritis confirmadas. Cuando ocurre, los patógenos de hongos y levaduras más comúnmente implicados son Aspergillus spp y Cándida spp, respectivamente, aunque se ha informado de una amplia gama de otros organismos. Se cree que la fuente más común de organismos infecciosos es la piel o las heces. Sin embargo, la colonización fúngica del útero es casi con certeza una condición oportunista, que depende de una alteración significativa y compromiso de los mecanismos de defensa normales vaginales y/o uterinos, o una inmunosupresión/compromiso más generalizado. Presumiblemente, esta es la razón por la que la endometritis fúngica se asocia comúnmente con antecedentes de neumovagina no corregida o endometritis post-reproducción persistente recurrente y, en particular, terapia con antibióticos intrauterinos (Stout, 2008).
Si bien la respuesta de la endometritis fúngica al tratamiento es generalmente mala, puede depender en parte de la identidad del organismo causal y la duración de la infección; p. ej., se cree que Cándida albicans puede penetrar más profundamente en el endometrio y/o crecer intracelularmente, donde será más resistente al aclaramiento del sistema inmunológico o de los antimicrobianos administrados por vía intrauterina. Se ha propuesto que tanto la colonización intracelular como un reservorio de infección no tratado en el tracto reproductivo caudal, contribuyen a la alta tasa de fracaso del tratamiento y/o recrudescencia (Stout, 2008).
Debido a que las condiciones exactas que permiten la colonización fúngica del útero son desconocidas, la reincidencia es común y actualmente no existen tratamientos probados que ofrezcan una alta probabilidad de resolución, por lo tanto, representa un desafío terapéutico considerable (Stout, 2008).
El uso de infusiones intrauterinas de antimicrobianos es beneficioso en casos de crecimiento bacteriano conocido que causa endometritis. Aunque se desconoce el mecanismo, las impresiones clínicas sugieren que el uso repetitivo, prolongado y excesivo de antimicrobianos parece estar asociado con un aumento en la incidencia de endometritis fúngica en yeguas (Hurtgen, 2006); se cree que la antibioticoterapia local prolongada altera los mecanismos de defensa que normalmente evitan que se establezcan hongos o levaduras, aunque no está claro cómo la administración intrauterina predispone a la infección por hongos, ya que no existe una flora uterina normal para interrumpir. Es más probable que el problema principal ocurra a nivel del tracto reproductivo caudal donde los antibióticos 'filtrados' del útero perturban la flora 'comensal', de tal manera que el crecimiento excesivo de hongos se ve facilitado por una competencia reducida, un pH vaginal alterado y, posiblemente, eliminación de bacterias capaces de segregar sustancias antifúngicas. De hecho, se cree que los hongos o levaduras que colonizan el útero, suelen derivar de un reservorio en la vagina y los genitales externos (Dascanio et al., 2001), y son transportados iatrogénicamente al útero durante la inseminación o el tratamiento intrauterino (Stout, 2008).
Si bien generalmente la respuesta de la endometritis fúngica al tratamiento no es alentadora generando un pronóstico malo a la reproducción, en muchos casos va a depender del agente causal. La infusión intrauterina de ácido acético al 2 % o de agentes antifúngicos específicos, parece ofrecer una tasa de resolución de poco más del 20 % por ciclo de tratamiento (Stout, 2008). Varios agentes antifúngicos, incluidos antibióticos poligénicos y derivados de azol, están disponibles y pueden usarse como estrategias de tratamiento. En el presente caso se usó como opción para terapia antimicótica el fluconazol oral, acompañado de un lavado uterino con ácido acético a una dilución acertada 2 %; según se reporta en la literatura, la eficacia de los imidazoles aumenta en combinación con ácido acético, puesto que este proporciona un ambiente ácido en el útero.
Para un mayor éxito del tratamiento, se utilizó la N-acetil cisteína como agente mucolítico, cuyo objetivo principal consiste en retirar la película bacteriana, debido a que su mecanismo de acción permite eliminar el exceso de moco y causar un mayor efecto bactericida al permitir una mejor absorción por parte de los antibióticos, en este caso, utilizados el Ceftiofur sódico y la ciprofloxacina, indicados para gram-y gram +, sensibles en el antibiograma y con propiedades farmacocinéticas y terapéuticas provechosas, ya que alcanzan concentraciones mininas inhibitorias (CMI) adecuadas en útero. Este plan terapéutico convencional, junto con la terapéutica complementaria, permitió evidenciar un útero limpio, con cambios de remodelación, epitelización y mejora del ambiente endometrial, lo que finalmente llevó a una fertilización y transferencia embrionaria exitosa. Se reporta que la infusión de N-acetilcisteína está asociada con una reacción inflamatoria aguda significativa y prolongada del endometrio (Caissie et al., 2020), lo cual parece deberse a su naturaleza hiperosmótica; sin embargo, se requieren estudios adicionales que permitan evaluar tratamientos alternativos con inmunomoduladores no irritantes, los cuales podrían llegar a normalizar la respuesta inflamatoria de las yeguas tratantes.
Se ha demostrado la importancia de la contractilidad uterina en la eliminación de bacterias, fluidos y productos inflamatorios del útero después de la reproducción. Es por esto, que el lavado uterino que fue utilizado en esta yegua está indicado para una mejora en la limpieza uterina consecuente de una baja contractilidad del miometrio, debido a que ayuda no solo con la inflamación sino también facilita la eliminación de líquido. Igualmente, se ha sugerido el uso de corticosteroides en yeguas con inflamación excesiva (Morales y Castro, 2018). Se recomienda la cirugía de Caslick para suturar la vulva en caballos de rendimiento con conformación perineal comprometida, para prevenir desafíos bacterianos repetitivos al tracto reproductivo y mejorar la fertilidad de las yeguas (Hurtgen, 2006).
El objetivo principal de un plan de diagnóstico y tratamiento para las yeguas problema, es determinar el pronóstico de las mismas para la reproducción y generar, en la medida de lo posible, un aumento en las tasas de preñez. El uso de vitaminas y de medicina biorreguladora concomitante con el tratamiento farmacológico antifúngico y antibiótico, además de la realización de los lavados, generó una mayor eficacia en el tratamiento, pudiendo finalmente recuperar embriones viables en esta yegua. La transferencia de embriones es una técnica de manejo que ha sido invaluable como método para obtener potros de yeguas con endometritis crónica persistente, muerte embrionaria temprana repetida o aborto, y endometritis persistente inducida por apareamiento, que no responde. Estas afecciones generalmente se complican por laceración cervical, edad avanzada de la yegua y endometritis bacteriana o fúngica.
El uso del lavado uterino, y empleo de sustancias ecbólicas e inseminación artificial con baja dosis antes y después de la ovulación, puede permitir que el útero apoye el desarrollo del embrión durante 7 a 10 días. El lavado uterino para recuperar uno o más embriones generalmente se realiza 7 u 8 días después de la ovulación; la tasa de recuperación de embriones suele estar en el rango de 70 a 80 % en yeguas sanas cruzadas con un semental fértil. En comparación, la tasa de recuperación embrionaria de yeguas infectadas crónicamente, manejadas intensivamente y criadas con sementales fértiles, suele ser del 25-40 %. La tasa de preñez después de la transferencia, es algo reducida para los embriones transferidos de yeguas infectadas crónicamente. Para evitar el entorno uterino hostil en el apareamiento o la transferencia de embriones, la transferencia de ovocitos puede ser otra técnica de manejo para obtener preñez de estos casos difíciles (Hurtgen, 2006).
Los aceites esenciales son mezclas complejas de varias sustancias que pueden actuar como agentes bacteriostáticos o bactericidas. Aquellos compuestos con acción antimicrobiana reconocida son los fenólicos y los terpenos; no obstante, existe la posibilidad de que haya un efecto sinérgico entre todos los componentes que mejora la actividad antimicrobiana general. El estudio in vitro llevado a cabo por Lisboa et al. (2022), se evidenció que los compuestos del aceite de Ocimum basilicum (albahaca) como estragol, linalol y eugenol, tienen actividades antimicrobianas prominentes contra microorganismos causantes de endometritis en yeguas (Lisboa et al., 2022).
También, se estudió que el quimiotipo borneol/ trans-ß-ocimeno/a -felandreno y canfeno del aceite Rosmarinus Officinalis (Romero) sugiere un efecto sinérgico determinante para la acción de este como agente antimicrobiano. En el caso de Cymbopogon citratus, este se compone principalmente de citral, que tiene un efecto inhibidor comprobado contra gram negativas (Badary y Abou, 2020), afectando las reacciones oxidativas biológicas y el ciclo de Krebs. Finalmente, este estudio concluye que los aceites esenciales pueden actuar como potenciadores de la actividad antimicrobiana, favoreciendo la acción de los antibióticos, incluso cuando ha surgido resistencia antibiótica o como atenua-dores de la virulencia, posiblemente a través de la modulación de la respuesta inmune del huésped frente a la infección (Badary y Abou, 2020), sugiriendo así, que el aceite de oliva, al pertenecer también a los aceites vegetales y ser rico en micronutrientes, pudo haber actuado en este caso como potencial antibacteriano.
El estudio llevado a cabo por Melguizo et al. (2021) en tejidos humanos, demostró que los compuestos del aceite de oliva, tenían propiedades antimicrobianas contra Staphylococcus aureus, Staphylococcus epidermidis, Escherichia coli, Proteus spp y Cándida Albicans (Rodríguez et al., 2021), sugiriendo actividad antimicrobiana contra gran parte de los agentes infecciosos reportados en yeguas con endometritis mencionadas anteriormente. Además, se encontró que todos los compuestos del aceite de oliva, exceptuando el ácido ferúlico, estimulan significativamente la capacidad proliferativa de fibroblastos, aumentando su migración y expresión de genes (Rodríguez et al., 2021) sugiriendo también su participación en los procesos de remodelación celular.
Los compuestos fenólicos del aceite de oliva también demuestran capacidad antioxidante, a través de su acción en la lisis de cadenas, donando radicales de hidrógeno a los radicales de alquilo piróxilo (Baldioli et al., 1996), producido por oxigenación de lípidos y dando lugar a la formación de derivados estables durante la reacción. Estas propiedades han atraído la atención hacia los compuestos fenólicos del aceite de oliva como posibles nutracéuticos, con el potencial de proteger contra enfermedades crónicas, degenerativas y asociadas al estrés oxidativo (García et al., 2018).
El oleocantal es un compuesto nutracéutico presente en el aceite de oliva extra virgen con propiedades beneficiosas para la salud, particularmente, su actividad antiinflamatoria se ha documentado, demostrando que este compuesto inhibe la actividad de la ciclooxigenasa -1 y ciclooxigenasa-2, evidenciado eficacia en muchas enfermedades caracterizadas por procesos inflamatorios crónicos (Esposito et al., 2022).
Lo anteriormente descrito, sugiere que el aceite de oliva administrado a la yegua de este caso, ofreció gran aporte terapéutico, gracias a sus propiedades antiinflamatorias, antioxidantes y antimicrobianas.
Se ha descubierto que varios micronutrien-tes influyen en el proceso de cicatrización, incluidos la vitamina A (Zinder et al., 2019), (Mohammed et al., 2016), y E (Hobson, 2016), cuya capacidad antioxidante se ha asociado con una mayor proliferación y diferenciación de fibroblastos, y una mayor producción de ácido hialurónico y colágeno, y cuya deficiencia se ha asociado con una menor actividad angiogénica, y mayor debilidad (Polcz y Barbul, 2019).
Los antioxidantes no enzimáticos como las vitaminas E y C, actúan para superar el estrés oxidativo. Algunos estudios han informado que una combinación de vitamina E y C reduce la peroxidación lipídica causada por sustancias tóxicas. Estas vitaminas inhiben la apoptosis mediada por radicales libres, eliminándolos directamente, mantienen la proteína Bcl-2 en su forma funcional por su acción estabilizadora de membrana, y por lo tanto, inhiben la liberación de citocromo C de las mitocondrias (Güney et al., 2007; Markiewicz et al., 2014).
Un estudio realizado por Wolf et al. (2012) acerca del efecto de la corticoterapia en la proteómica del líquido endometrial de yeguas susceptibles a endometritis, sugiere que el aumento de la frecuencia de la transtiretina inducida por la corticoterapia se asocia a la protección del tejido inflamado, por el transporte de la vitamina A. La transtiretina tiene un papel importante en el transporte de retinol, y se sugiere que esta vitamina es necesaria para la síntesis de glicoproteínas (Wolf et al., 2012), por lo que participaría en procesos de epitelización y remodelamiento. De igual forma, los derivados del retinol y la vitamina A, afectan la diferenciación celular, la proliferación y la apoptosis, y desempeñan un papel esencial en diversos procesos biológicos (Atti-Santos et al., 2005).
Según un estudio realizado por Ling et al. (2018), el receptor de vitamina D controla la renovación y activación de células madre durante la reparación de lesiones a través de la vía de la ß- catenina (Ling et al., 2018). Además, muchos estudios demostraron que la vitamina D3 posee propiedades inmunomoduladoras pronunciadas tanto en el sistema inmune innato como adaptativo, proponiendo que podría influir en la actividad local de células inmuni-tarias que desempeñan funciones patogénicas importantes en el desarrollo y mantenimiento de la endometriosis. Distintos tipos de células inmunitarias, incluyendo monocitos, y linfocitos T y B expresan el receptor de vitamina D, y poseen actividad 1α - hidroxilasa que es la enzima que cataliza la síntesis de la vitamina (Abbas et al., 2013).
Teniendo en cuenta lo anteriormente mencionado, se justifica el uso de productos como el Vigantol®, altos en contenido vitamínico, ya que funcionan como antioxidantes, inmuno-moduladores y pro-remodeladores del tejido endometrial.
El fósforo participa en el metabolismo de energía y fosfolípidos (Kumar et al., 2020); hace parte fundamental de los ácidos nucleicos, desempeña una actividad fundamental en el metabolismo como ATP y coenzimas similares, transfiere energía química y apoya la estructura celular fosfolipídica (Pasek, 2019).
El magnesio está involucrado en todas las reacciones enzimáticas, incluyendo la utilización y formación de ATP; es indispensable para todas las reacciones de transferencia de fosfato, estabiliza cargas aniónicas en el ATP, ADP y AMP, actúa como co-factor para las reacciones que requieren pirofosfato de tiamina, y participa en la síntesis de ácido nucleico y la utilización de Acetil CoA. El magnesio ejerce muchos efectos regulatorios en la función de la membrana celular, la conductividad eléctrica y la señalización hormonal de procesos intracelulares. Es indispensable para la activación de varios sistemas enzimáticos (Kumar et al., 2020).
Hay muchas proteínas que contienen selenio que funcionan como enzimas, como, p. ej., la glutatión peroxidasa, que es una enzima antioxidante que ayuda a proteger de la actividad oxidativa producida por las especies reactivas de oxígeno y los radicales libres, que pueden llevar al daño de las membranas celulares. Existen además otras 25 proteínas conocidas que contienen selenio y que, de forma sinérgi-ca, son vitales para el óptimo funcionamiento de los sistemas antioxidantes, inmunológicos y musculoesqueléticos. Por lo tanto, el selenio en una yegua de cría es importante para mantener el nivel óptimo de las selenoproteínas, que contribuyen a la actividad antioxidante y las defensas; demostrando la importancia de este mineral para todos los aspectos del ciclo reproductivo, incluidos la fertilidad, el crecimiento fetal, el parto, la lactancia y la inmunocompetencia del potro (Dunnett, 2008).
La relevancia del selenio dietético para la en-dometritis se revela al examinar el efecto de esta enfermedad sobre indicadores de daño oxidativo. Se informa que la actividad de la glutatión peroxidasa está disminuida en yeguas con endometritis (Dunnett, 2008).
El Zinc es un oligoelemento vital para el organismo, y su biodisponibilidad influye en distintos eventos reproductivos. Está involucrado en procesos celulares como la proliferación, la función inmunitaria, la defensa antioxidante, la expresión génica, y la actividad de la ARN polimerasa. En mamíferos, la homeostasis de este oligoelemento es esencial para la función metabólica adecuada en procesos reproductivos; su biodisponibilidad es beneficiosa para el crecimiento folicular, la maduración de ovocitos, la fertilización, y el desarrollo embrionario (Pascua et al., 2020).
El zinc participa de forma esencial en diversos procesos celulares que involucran: interleucina-6, lipopolisacáridos, factores de transcripción, estrés oxidativo, hipoxia y hormonas sexuales (Pascua et al., 2020).
El zinc como antioxidante indirecto, es un componente del superóxido dismutasa citoplasmático, uno de los elementos de defensa contra el estrés oxidativo del organismo (Madej et al., 2021).
Según un artículo publicado por Nasiadek et al. (2020), acerca del papel del zinc en trastornos del sistema reproductor femenino humano, este microelemento es crucial para la regulación del crecimiento celular, la liberación de hormonas, la respuesta inmunológica y la reproducción, ya que desempeña un papel crítico en la fertilidad, actuando como cofactor en las enzimas del ciclo del folato, involucradas en el reciclaje de la homocisteína a metionina (Nasiadek et al., 2020).
Los minerales traza como el Zn, Mn, Cu y Co tienen funciones importantes en la síntesis de proteínas, el metabolismo de vitaminas, la formación de tejido conectivo y la función inmunológica (Griffiths et al., 2007).
Los micronutrientes tienen un papel central en el metabolismo y mantenimiento de la función tisular. El zinc y el cobre son esenciales para el crecimiento, desarrollo, células del sistema inmune y para la actividad de muchas enzimas (Abo et al., 2012).
El cobre es un ion metálico con funciones conocidas en asociación con proteínas y enzimas esenciales para los procesos celulares. Se ha demostrado que el cobre influye en la biología reproductiva de los mamíferos y que ejerce efectos importantes a nivel de la glándula pituitaria y/o regiones hipotalámicas del cerebro (Peacey et al., 2020).
El cobre puede actuar como cofactor estructural y/o regulador de distintas proteínas, pero se une predominantemente a enzimas que explotan la capacidad redox del metal (Peacey et al., 2020).
El cobre está involucrado con enzimas esteroidogénicas y es importante para la regulación de la producción de progesterona a través de su participación en la superóxido dismutasa. Está involucrado en reacciones enzimáticas asociadas al metabolismo de los carbohidratos, de los ácidos nucleicos y la síntesis de proteínas, por lo que su papel en las gónadas es esencial debido al crecimiento activo y la división que se produce allí. También, está involucrado en el establecimiento de prostaglandinas, porque las enzimas Zn regulan la cascada del ácido araquidónico. Estos factores de crecimiento participan en la remodelación uterina (Springman et al., 2021).
Los hallazgos bibliográficos anteriormente descritos acerca del papel y la función celular de distintos macro y microminerales, justifica el uso de complejos como el vitasel en el tratamiento integral de la endometritis, porque su adecuado contenido de elementos como el Zn, Mg, Cu, Se y P, cumple funciones antioxidantes, inmunomoduladoras, enzimáticas, antiinflamatorias, estructurales, entre otras que apoyan la recuperación y remodelación del tejido uterino / endometrial, al mismo tiempo que contribuye en la recuperación de la función y actividad reproductiva de la yegua.
Se reporta el caso de una yegua criolla colombiana de cinco años, con alto valor genético e historial de problemas reproductivos con ciclos estrales irregulares, dificultad para obtener embriones y el mantenimiento de una preñez. El diagnóstico concluye mosaicismo infértil. La terapéutica inicial hormonal fue insatisfactoria, por lo que se optó por un tratamiento biorregulador intravenoso que combinaba: Coenzime Compositum®, Ovarium Compositum®, Nuxe-el®, Berbeel®, Lymphomyosot®, Hormeel®, e Hyphophysis suis®, del cual se obtuvieron resultados exitosos con la activación del sistema hormonal y reproductivo, a partir de la autorregulación del eje hipotálamo-hipófisis-ovario (Duarte, 2020).
Otro reporte de caso de una yegua de paso fino colombiano con falla ovulatoria, publicado por Otálvaro et al. (2009), describe el tratamiento combinado homeopático antihomotóxico y hormonal ofrecido. Se utilizó: Ovarium compositum®, Damiana injeel®, Cerebrum compositum®, y Phosphor homaccord® durante mes y medio, así como una terapia neural. Debido a que no se obtuvo respuesta ovulatoria, se procedió al tratamiento hormonal con hCG, luego de lo cual el celo se hizo evidente cinco días después, se procedió a realizar la inseminación artificial, pero la preñez se perdió 40 días después; a pesar de ello, la yegua volvió al estro 20 días después, se inseminó nuevamente, y se obtuvo una gestación y parto exitosos. Este informe sugiere terapia hormonal junto con medicina alternativa para el tratamiento de patologías ováricas específicas en yeguas (Otálvaro et al., 2009).
Un estudio realizado por Bogdan et al. (2009), probó la eficacia de dos métodos de tratamiento homeopáticos que se pueden utilizar para el tratamiento de endometritis crónica en vacas. Se prepararon dos lotes experimentales, donde uno se trató con Lachesis compositum® (Biologische Heilmittel Heel GmbH, Baden-Baden, Alemania) que obtuvo un éxito terapéutico de 81,5 % y otro con Mucosa Compositum® (Biologische Heilmittel Heel GmbH, Baden-Baden, Alemania) que obtuvo un éxito terapeútico de un 73.3 %, junto con un lote de control que no utilizó medicación homeopática y obtuvo porcentajes de éxito terapéutico considerablemente más bajos. Los resultados obtenidos demostraron que la terapia homeopática proporcionó una estimulación inmunológica importante que contribuyó a superar la infección uterina (Bodgan et al., 2009).
Un estudio publicado por Kumar et al. (2018), acerca de los aspectos actuales del tratamiento de los trastornos reproductivos bovinos, concluyó las preparaciones a base de hierbas y los inmunomoduladores tienen el potencial de impulsar la inmunidad y la mejora del proceso natural del organismo para combatir enfermedades. Sin embargo, se requiere de una terapia médica, nutrición y otros aspectos de gestión que también desempeñan un papel importante en el sistema de producción (Kumar et al., 2018).
La revisión bibliográfica anterior expone diversos casos tanto en yeguas como otras especies veterinarias, donde la utilización de productos homeopáticos y de medicina biorreguladora resultó ser exitoso para el tratamiento de afecciones reproductivas, gracias a sus propiedades inmunoestimulantes, antiinflamatorias, detoxificantes y reguladoras. Sin embargo, cabe resaltar que el uso de las mismas es individual y específico para cada animal, y que preferiblemente debe usarse en conjunto con la terapéutica convencional, con el fin de potenciar la interacción de cada componente administrado, pudiendo utilizarse estas terapias tanto como alternativas como coadyuvantes en distintas patologías.
El tratamiento es un abordaje clínico integral, es decir, no solo objetiva mejorar el puntaje de condición corporal, sino también el empleo de terapias de medicina convencional, no convencional, terapia intrauterina específica, preservando la integridad del endometrio, promoviendo la epitelización del endometrio, y el empleo de nutraceúticos y medicina biorregu-ladora de sistemas es crucial.
El tratamiento de este tipo de endometritis es complejo, ya que requiere del acompañamiento personalizado por parte del médico veterinario, es costoso, y demora entre tres a cuatro meses para posteriormente iniciar protocolos de lavados de embriones a los ocho meses, y de esta forma poder obtener resultados significativos.
La endometritis fúngica, aunque poco común, al igual que las demás endometritis, constituye un problema de fertilidad en las yeguas. Su detección y oportuno tratamiento representan un desafío clínico para los médicos veterinarios. Generalmente, su pronóstico es de reservado a malo para la reproducción, sin embargo, la detección precisa de los patógenos causantes es concluyente y permite la instauración de un tratamiento adecuado, mejorando así el pronóstico y aumentando la tasa de preñez en las yeguas tratadas. El examen de solidez reproductiva brinda una vista amplia del estado reproductivo de las yeguas problema, por lo cual es determinante para el diagnóstico de patologías reproductivas.
La detección de la endometritis, ya sea de etiología bacteriana o fúngica, se realiza con base en el histórico reproductivo, repetición de servicios, tipo de secreción intrauterina, presencia de distopias vulvares, y problemas a nivel de cervix.
Para establecer el diagnóstico definitivo, es necesario emplear pruebas como citología endometrial, cultivo endometrial, específicamente el agar saboreau, el cual es un medio de cultivo sensible para diagnosticar la presencia de hongos; además, se realizan pruebas bioquímicas, y la prueba de la biopsia endometrial, considerada como Gold Estándar.
A los propietarios de la paciente, por permitirnos desarrollar este caso y poner a nuestra disposición el lugar para llevar a cabo nuestra investigación, la cual se hizo con recursos propios.
*Autor de correspondencia. Correo electrónico: bioanimalsas@gmail.com